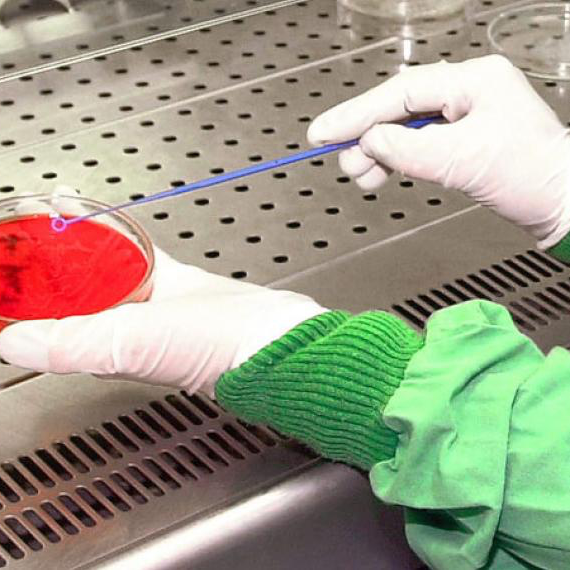

The Centre has a total of 17,500 m2 located in the town centre of the municipality and has, among others, the following facilities:
Vegetable canning pilot plant
Food industry laboratory
Environmental laboratory
Tasting room
Meat and pre-cooked meats and ready meals workshop
Technology, electricity and cold storage workshop classroom
Computer room
Conference hall
Residence and canteen
General view of the building